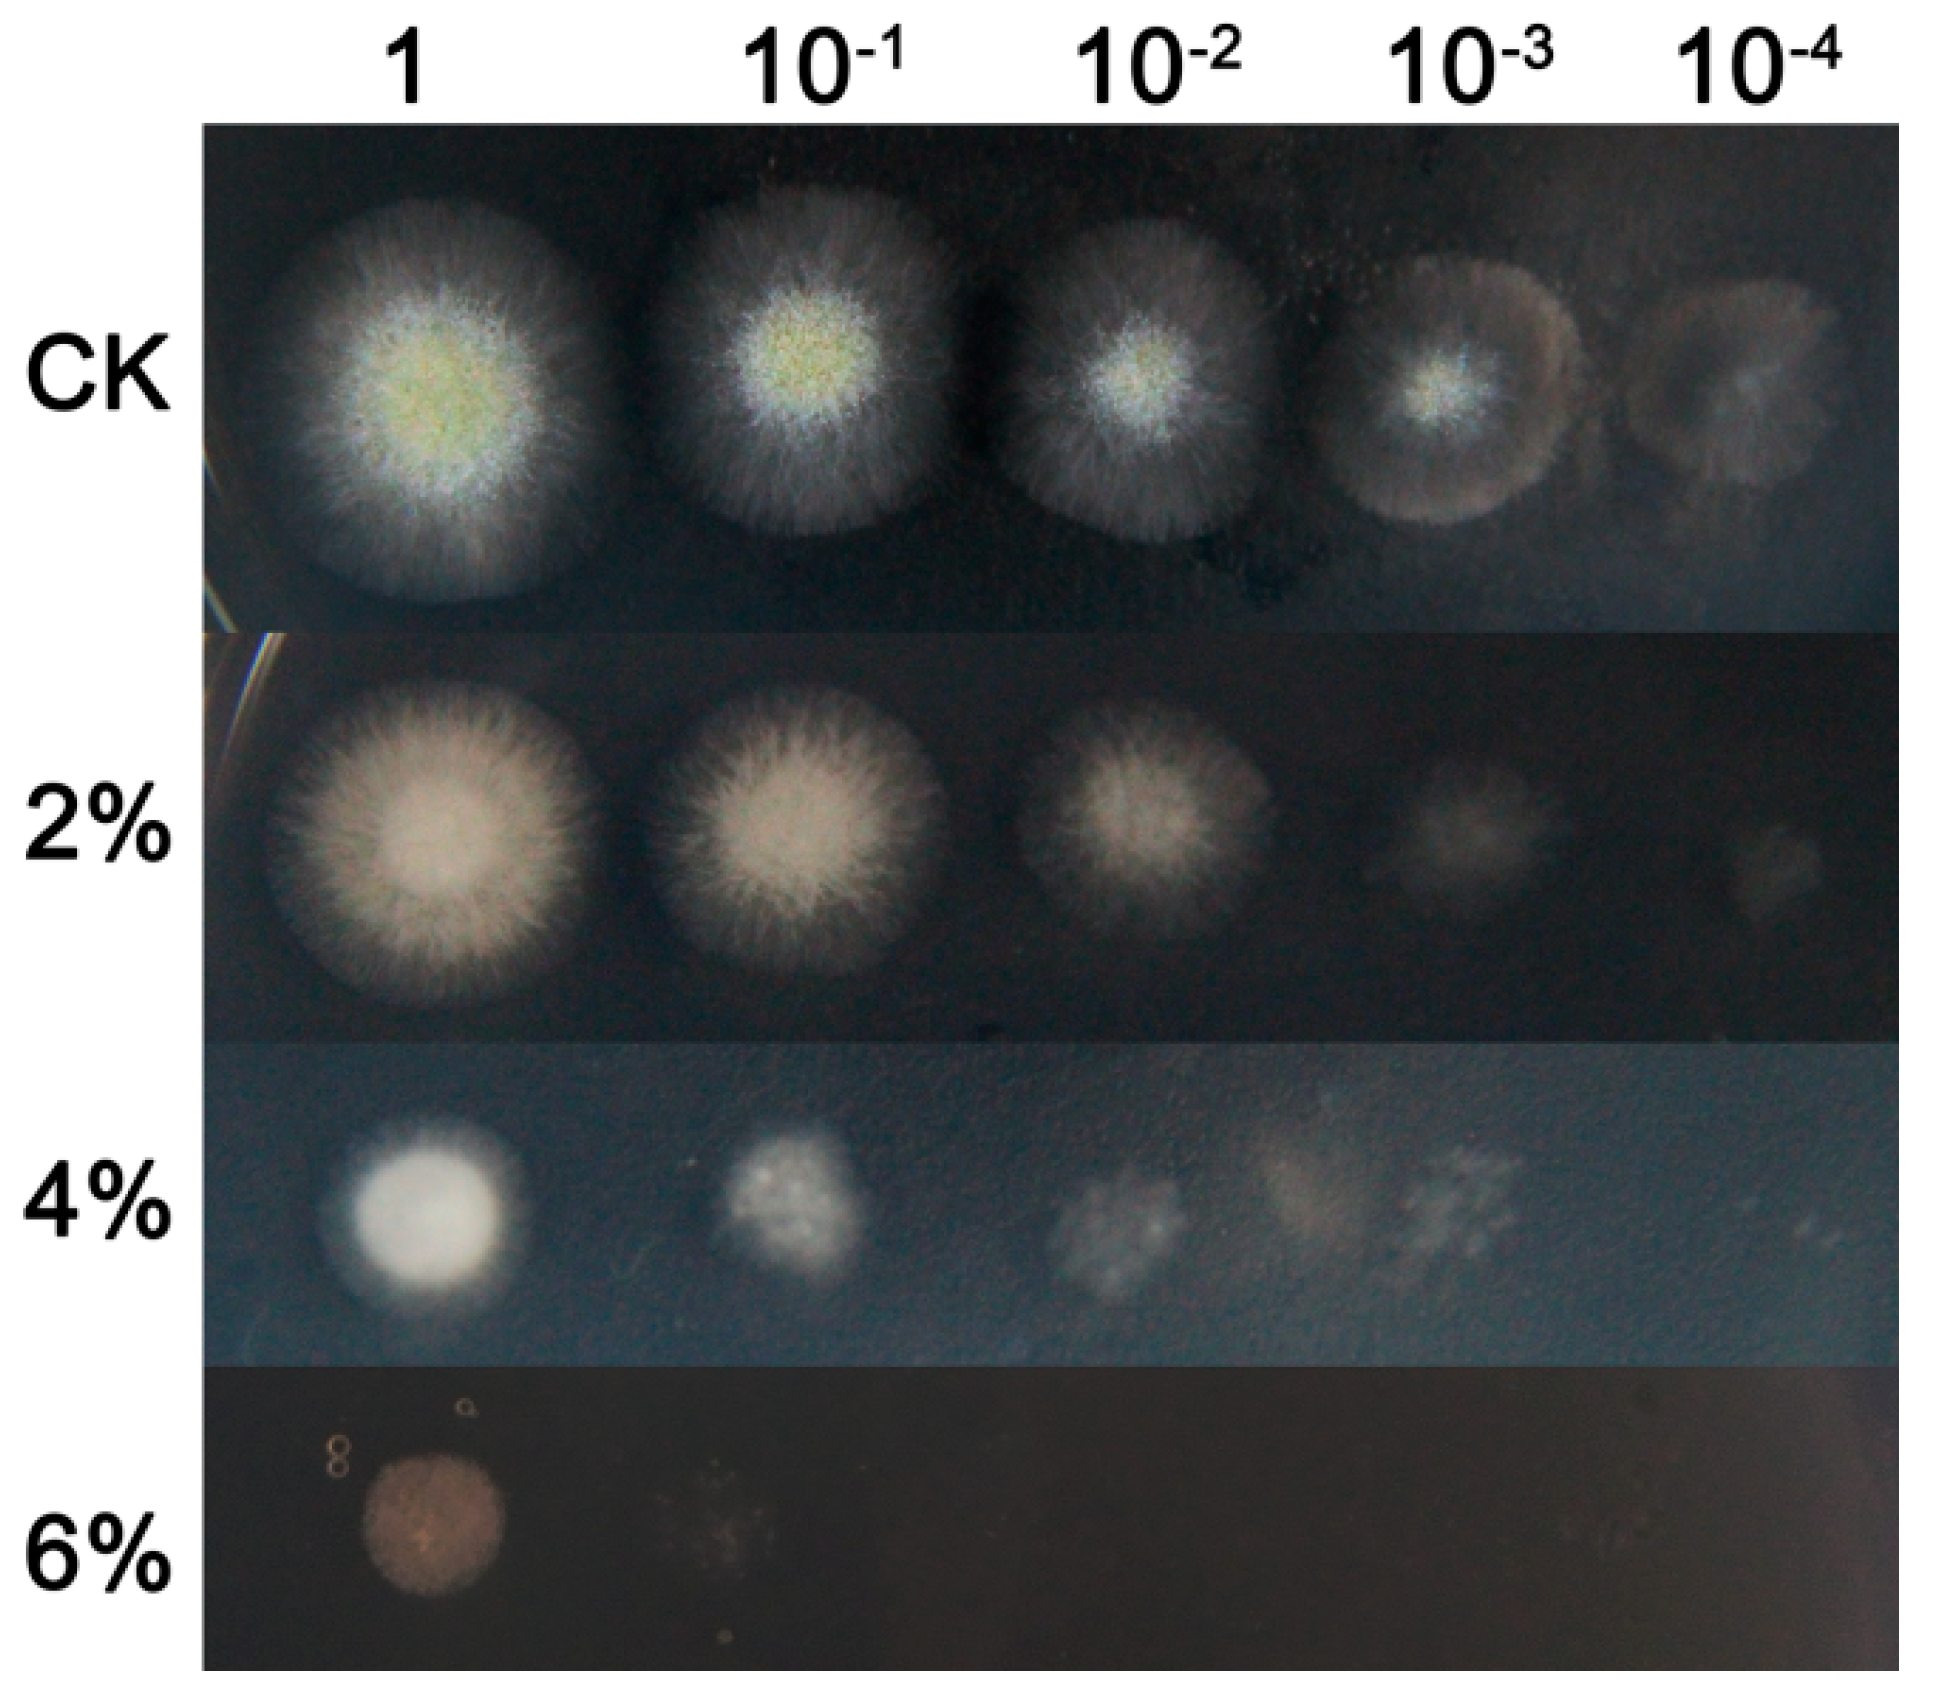
Microorganisms 07 00158 g001 550

Modulation of Fatty Acid Composition of Aspergillus oryzae in Response to Ethanol Stress
Abstract
:1. Introduction
2. Materials and Methods
2.1. Effects of Ethanol Stress on A. oryzae
2.2. Transmission Electron Microscopy (TEM) Analysis
2.3. Determination of Cellular Fatty Acid Content
2.4. Effects of Ethanol Stress on Gene Transcription
2.5. Determination of Intracellular Free Amino Acids
2.6. Data Analysis
3. Results
3.1. Effect of Ethanol Stress on Growth and Development of A. oryzae
3.2. Morphological Changes under Ethanol Treatment
3.3. Determination of Intracellular Fatty Acid Compositions
3.4. Differential Expression of Desaturases in Linoleic Acid Biosynthesis
3.5. Determination of Intracellular Free Amino Acids
4. Discussion
Supplementary Materials
Author Contributions
Funding
Acknowledgments
Conflicts of Interest
References
- Akasaka, N.; Kato, S.; Kato, S.; Hidese, R.; Wagu, Y.; Sakoda, H.; Fujiwara, S. Agmatine production by Aspergillus oryzae is elevated by low pH during solid–state cultivation. Appl. Environ. Microbiol. 2018, 84, e00722-18. [Google Scholar] [CrossRef]
- Sato, Y.; Fukuda, H.; Zhou, Y.; Mikami, S. Contribution of ethanol–tolerant xylanase G2 from Aspergillus oryzae on Japanese sake brewing. J. Biosci. Bioeng. 2010, 110, 679–683. [Google Scholar] [CrossRef]
- Kotaka, A.; Bando, H.; Kaya, M.; Kato–Murai, M.; Kuroda, K.; Sahara, H.; Hata, Y.; Kondo, A.; Ueda, M. Direct ethanol production from barley beta–glucan by sake yeast displaying Aspergillus oryzae beta–glucosidase and endoglucanase. J. Biosci. Bioeng. 2008, 105, 622–627. [Google Scholar] [CrossRef]
- Gibson, B.R.; Lawrence, S.J.; Leclaire, J.P.; Powell, C.D.; Smart, K.A. Yeast responses to stresses associated with industrial brewery handling. FEMS Microbiol. Rev. 2007, 31, 535–569. [Google Scholar] [CrossRef] [PubMed]
- Kim, S.; Kim, J.; Song, J.H.; Jung, Y.H.; Choi, I.S.; Choi, W.; Park, Y.C.; Seo, J.H.; Kim, K.H. Elucidation of ethanol tolerance mechanisms in Saccharomyces cerevisiae by global metaboliteprofiling. Biotechnol. J. 2016, 11, 1221–1229. [Google Scholar] [CrossRef] [PubMed]
- Pascual, C.; Alonso, A.; Garcia, I.; Romay, C.; Kotyk, A. Effect of ethanol on glucose transport, key glycolytic enzymes, and proton extrusion in Saccharomyces cerevisiae. Biotechnol. Bioeng. 1988, 32, 374e378. [Google Scholar] [CrossRef] [PubMed]
- Ma, M.; Liu, Z.L. Mechanisms of ethanol tolerance in Saccharomyces cerevisiae. Appl. Microbiol. Biotechnol. 2010, 87, 829–845. [Google Scholar] [CrossRef] [PubMed]
- Sajbidor, J.; Ciesarova, Z.; Smogrovicova, D. Influence of ethanol on the lipid content and fatty acid composition of Saccharomyces cerevisiae. Folia Microbiol. 1995, 40, 508–510. [Google Scholar] [CrossRef]
- You, K.M.; Rosenfield, C.L.; Knipple, D.C. Ethanol tolerance inthe yeast Saccharomyces cerevisiae is dependent on cellular oleic acidcontent. Appl. Environ. Microbiol. 2003, 69, 1499–1503. [Google Scholar] [CrossRef]
- Dong, S.J.; Yi, C.F.; Li, H. Changes of Saccharomyces cerevisiae cell membrane components and promotion to ethanol tolerance during the bioethanol fermentation. Int. J. Biochem. Cell Biol. 2015, 69, 196–203. [Google Scholar] [CrossRef]
- Henderson, C.M.; Block, D.E. Examining the role of membrane lipid composition in determining the ethanol tolerance of Saccharomyces cerevisiae. Appl. Environ. Microbiol. 2014, 80, 2966–2972. [Google Scholar] [CrossRef]
- Weber, F.J.; de Bont, J.A.M. Adaptation mechanisms of microorganisms to the toxic effects of organic solvents on membranes. Biochim. Biophys. Acta 1996, 1286, 225–245. [Google Scholar] [CrossRef]
- Abe, F.; Hiraki, T. Mechanistic role of ergosterol in membrane rigidity and cycloheximide resistance in Saccharomyces cerevisiae. Biochim. Biophys. Acta. 2009, 1788, 743e752. [Google Scholar] [CrossRef]
- Auesukaree, C.; Damnernsawad, A.; Kruatrachue, M.; Pokethitiyook, P.; Boonchird, C.; Kaneko, Y.; Harashima, S. Genome-wide identification of genes involved in tolerance to various environmental stresses in Saccharomyces cerevisiae. J. Appl. Genet. 2009, 50, 301e310. [Google Scholar] [CrossRef]
- Teixeira, M.C.; Raposo, L.R.; Mira, N.P.; Lourenco, A.B.; Sa-Correia, I. Genome-wide identification of Saccharomyces cerevisiae genes required for maximal tolerance to ethanol. Appl. Environ. Microbiol. 2009, 75, 5761e5772. [Google Scholar] [CrossRef]
- Verghese, J.; Abrams, J.; Wang, Y.; Morano, K.A. Biology of the heat shock response and protein chaperones: Budding yeast (Saccharomyces cerevisiae) as a model system. Microbiol. Mol. Biol. Rev. 2012, 76, 115e158. [Google Scholar] [CrossRef]
- Sanchez, Y.; Taulien, J.; Borkovich, K.A.; Lindquist, S. Hsp104 is required for tolerance to many forms of stress. EMBO J. 1992, 11, 2357e2364. [Google Scholar] [CrossRef]
- Yoshikawa, K.; Tanaka, T.; Furusawa, C.; Nagahisa, K.; Hirasawa, T.; Shimizu, H. Comprehensive phenotypic analysis for identification of genes affecting growth under ethanol stress in Saccharomyces cerevisiae. FEMS Yeast Res. 2009, 9, 32–44. [Google Scholar] [CrossRef] [PubMed]
- Jain, N.K.; Roy, I. Effect of trehalose on protein structure. Protein Sci. 2009, 18, 24e36. [Google Scholar] [CrossRef]
- Divate, N.R.; Chen, G.H.; Wang, P.M.; Ou, B.R.; Chung, Y.C. Engineering Saccharomyces cerevisiae for improvement in ethanol tolerance by accumulation of trehalose. Bioengineered 2016, 7, 445–458. [Google Scholar] [CrossRef] [PubMed]
- Takagi, H. Proline as a stress protectant in yeast: physiological functions, metabolic regulations and biotechnological applications. Appl. Microbiol. Biotechnol. 2008, 81, 211–223. [Google Scholar] [CrossRef] [PubMed]
- Takagi, H.; Taguchi, J.; Kaino, T. Proline accumulation protects Saccharomyces cerevisiae cells in stationary phase from ethanol stress by reducing reactive oxygen species levels. Yeast 2016, 33, 355–363. [Google Scholar] [CrossRef] [PubMed]
- Morard, M.; Macías, L.G.; Adam, A.C.; Lairón-Peris, M.; Pérez-Torrado, R.; Toft, C.; Barrio, E. Aneuploidy and Ethanol Tolerance in Saccharomyces cerevisiae. Front. Genet. 2019, 10, 82. [Google Scholar] [CrossRef]
- Zhao, G.; Yao, Y.; Chen, W.; Cao, X. Comparison and analysis of the genomes of two Aspergillus oryzae strains. J. Agric. Food Chem. 2013, 61, 7805–7809. [Google Scholar] [CrossRef]
- Mannazzu, I.; Angelozzi, D.; Belviso, S.; Budroni, M.; Farris, G.; Goffrini, P.; Lodi, T.; Marzona, M.; Bardi, L. Behaviour of Saccharomyces cerevisiae wine strains during adaptation to unfavourable conditions of fermentation on synthetic medium: cell lipid composition, membrane integrity, viability and fermentative activity. Int. J. Food Microbiol. 2008, 121, 84–91. [Google Scholar] [CrossRef]
- Benjaphokee, S.; Hasegawa, D.; Yokota, D.; Asvarak, T.; Auesukaree, C.; Sugiyama, M.; Kaneko, Y.; Boonchird, C.; Harashima, S. Highly efficient bioethanol production by a Saccharomyces cerevisiae strain with multiple stress tolerance to high temperature, acid and ethanol. New Biotechnol. 2012, 29, 379–386. [Google Scholar] [CrossRef] [PubMed]
- Cheng, Y.; Du, Z.; Zhu, H.; Guo, X.; He, X. Protective effects of arginine on Saccharomyces cerevisiae against ethanol stress. Sci. Rep. 2016, 6, 31311. [Google Scholar] [CrossRef]
- Srivastava, A.; Singh, S.S.; Mishra, A.K. Modulation in fatty acid composition influences salinity stress tolerance in Frankia strains. Ann. Microbiol. 2014, 64, 1315–1323. [Google Scholar] [CrossRef]
- He, B.; Ma, L.; Hu, Z.; Li, H.; Ai, M.; Long, C.; Zeng, B. Deep sequencing analysis of transcriptomes in Aspergillus oryzae in response to salinity stress. Appl. Microbiol. Biotechnol. 2018, 102, 897–906. [Google Scholar] [CrossRef] [PubMed]
- Luo, J.; Song, Z.; Ning, J.; Cheng, Y.; Wang, Y.; Cui, F.; Shen, Y.; Wang, M. The ethanol-induced global alteration in Arthrobacter simplex and its mutants with enhanced ethanol tolerance. Appl. Microbiol. Biotechnol 2018, 102, 9331–9350. [Google Scholar] [CrossRef]
- Turk, M.; Méjanelle, L.; Sentjurc, M.; Grimalt, J.O.; Gunde–Cimerman, N.; Plemenitas, A. Salt–induced changes in lipid composition and membrane fluidity of halophilic yeast–like melanized fungi. Extremophiles 2004, 8, 53–61. [Google Scholar] [CrossRef] [PubMed]
- Mutnuri, S.; Vasudevan, N.M.; Heipieper, H.J. Changes in fatty acid composition of Chromohalobacter israelensis with varying salt concentrations. Curr. Microbiol. 2005, 50, 151–154. [Google Scholar] [CrossRef] [PubMed]
- Zhang, J.T.; Zhu, J.Q.; Zhu, Q.; Liu, H.; Gao, X.S.; Zhang, H.X. Fatty acid desaturase–6 (Fad6) is required for salt tolerance in Arabidopsis thaliana. Biochem. Biophys. Res. Commun. 2009, 390, 469–474. [Google Scholar] [CrossRef] [PubMed]
- Tasaka, Y.; Gombos, Z.; Nishiyama, Y.; Mohanty, P.; Ohba, T.; Ohki, K.; Murata, N. Targeted mutagenesis of acyl–lipid desaturases in Synechocystis: Evidence for the important roles of polyunsaturated membrane lipids in growth, respiration and photosynthesis. EMBO J. 1996, 15, 6416–6425. [Google Scholar] [CrossRef]
- Weber, M.H.; Klein, W.; Muller, L.; Niess, U.M.; Marahiel, M.A. Role of the Bacillus subtilis fatty acid desaturase in membrane adaptation during cold shock. Mol. Microbiol. 2001, 39, 1321–1329. [Google Scholar] [CrossRef] [PubMed]
- Kasavi, C.; Eraslan, S.; Oner, E.T.; Kirdar, B. An integrative analysis of transcriptomic response of ethanol tolerant strains to ethanol in Saccharomyces cerevisiae. Mol. Biosyst. 2016, 12, 464–476. [Google Scholar] [CrossRef]
- Yale, J.; Bohnert, H.J. Transcript expression in Saccharomyces cerevisiae at high salinity. J. Biol. Chem. 2001, 276, 15996–16007. [Google Scholar] [CrossRef] [PubMed]
- Alexandre, H.; Ansanay-Galeote, V.; Dequin, S.; Blondin, B. Global gene expression during short-term ethanol stress in Saccharomyces cerevisiae. FEBS Lett. 2001, 498, 98–103. [Google Scholar] [CrossRef]
- Ghosh, R.; Sharma, S.; Chattopadhyay, K. Effect of arginine on protein aggregation studied by fluorescence correlation spectroscopy and other biophysical method. Biochemistry 2009, 48, 1135–1143. [Google Scholar] [CrossRef]
- Bearson, B.L.; Lee, I.S.; Casey, T.A. Escherichia coli O157: H7 glutamate– and arginine–dependent acid–resistance systems protect against oxidative stress during extreme acid challenge. Microbiology 2009, 155, 805–812. [Google Scholar] [CrossRef]
- Xu, S.; Zhou, J.; Liu, L.; Chen, J. Arginine: A novel compatible solute to protect Candida glabrata against hyperosmotic stress. Process. Biochem. 2011, 46, 1230–1235. [Google Scholar] [CrossRef]
- Sun, Y.; Niu, Y.; He, B.; Ma, L.; Li, G.; Tran, V.T.; Zeng, B.; Hu, Z. A Dual Selection Marker Transformation System Using Agrobacterium tumefaciens for the Industrial Aspergillus oryzae 3.042. J. Microbiol. Biotechnol. 2019, 29, 230–234. [Google Scholar] [CrossRef] [PubMed]
- Nguyen, K.T.; Ho, Q.N.; Do, L.T.B.X.; Mai, L.T.D.; Pham, D.N.; Tran, H.T.T.; Le, D.H.; Nguyen, H.Q.; Tran, V.T. A new and efficient approach for construction of uridine/uracil auxotrophic mutants in the filamentous fungus Aspergillus oryzae using Agrobacterium tumefaciens–mediated transformation. World J. Microbiol. Biotechnol. 2017, 33, 107. [Google Scholar] [CrossRef] [PubMed]

© 2019 by the authors. Licensee MDPI, Basel, Switzerland. This article is an open access article distributed under the terms and conditions of the Creative Commons Attribution (CC BY) license (http://creativecommons.org/licenses/by/4.0/).
Share and Cite
Ma, L.; Fu, L.; Hu, Z.; Li, Y.; Zheng, X.; Zhang, Z.; Jiang, C.; Zeng, B. Modulation of Fatty Acid Composition of Aspergillus oryzae in Response to Ethanol Stress. Microorganisms 2019, 7, 158. https://doi.org/10.3390/microorganisms7060158
Ma L, Fu L, Hu Z, Li Y, Zheng X, Zhang Z, Jiang C, Zeng B. Modulation of Fatty Acid Composition of Aspergillus oryzae in Response to Ethanol Stress. Microorganisms. 2019; 7(6):158. https://doi.org/10.3390/microorganisms7060158
Chicago/Turabian StyleMa, Long, Lijun Fu, Zhihong Hu, Yongkai Li, Xing Zheng, Zhe Zhang, Chunmiao Jiang, and Bin Zeng. 2019. "Modulation of Fatty Acid Composition of Aspergillus oryzae in Response to Ethanol Stress" Microorganisms 7, no. 6: 158. https://doi.org/10.3390/microorganisms7060158
APA StyleMa, L., Fu, L., Hu, Z., Li, Y., Zheng, X., Zhang, Z., Jiang, C., & Zeng, B. (2019). Modulation of Fatty Acid Composition of Aspergillus oryzae in Response to Ethanol Stress. Microorganisms, 7(6), 158. https://doi.org/10.3390/microorganisms7060158

